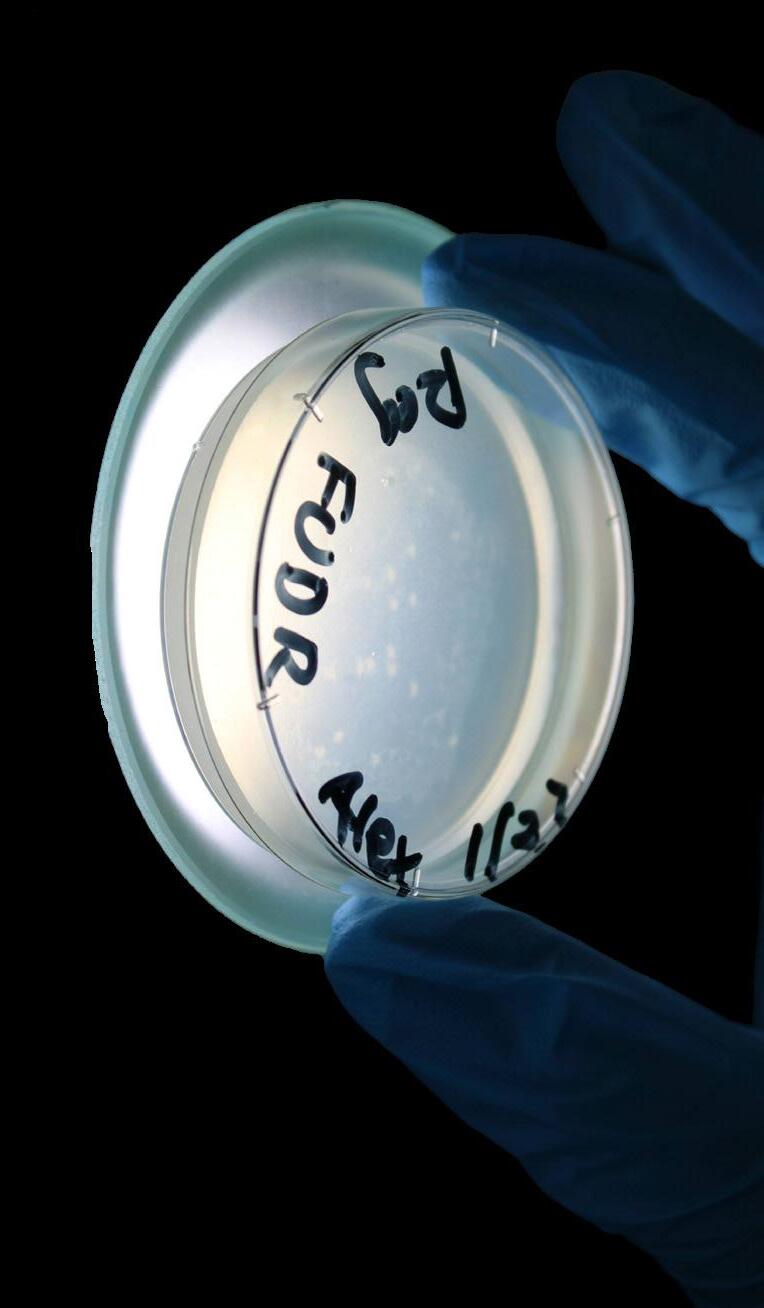

![]()














































































































































































































































































































































































































































































































































































































Editors-in-Chief
Andi Jacobs & Sophie Smith
Managing Editor
Jack Robinson
Assc. Managing Editors
Avni Krishna & Catie Campagnino

Creative Directors
Bianca Mastocciolo & Camille Blundell

Editors

Sutton Bulkeley
Camilla Garfield
Nate Gerber

Zoya Gill
Serena Goldfarb
Chloe Mitchell
Dylan Robbin
Business Manager
Olivia Saw
Joseph DelGobbo &
Mary Elizabeth Fulco

ings News is uncensored, unedited by administration, and does not allow for prior review.

The decisions of Inklings News and Westport Public Schools are made without regard to race, color, age, sex,religion, national origin, sexual orientation, marital status, disability or any other discriminating basis prohibited by local, state or federal law
The cover of Common Threads compiled some features photos and stories into an intricate, quilted design. Cover by Creative Directors.
Inklings News reserves the right to not publish advertisements that promote products that could be harmful to student health.















































Iimagine that you, loyal reader, may be wondering, “How do the fiber arts relate to the wider Staples community?” And in truth, I wasn’t so sure myself until a month ago.


























































































When I was tasked with coming up with a theme for this supplemental issue of Inklings, anyone could tell you that I kept my secretive and complex thought process to myself for a much longer time than I should have. While I’d love to claim that was to create a mystique and sense of wonder, the harsh reality was that I had no idea what to do.
To try and get a sense of how clueless I was, I opened up a dusty Google Doc from November titled “supp theme ideas masterdoc,” and found that the only writing in it was two words: “supp themes.” Eventually, I came up with two grand ideas, one focusing on the past, present and future of Staples, and another interviewing the most interesting and accomplished people around the school.














Two weeks later, when I hated those ideas, I reflected with the help of just about everyone I knew on what I really valued about Staples, and our town community as a whole. I wanted to create an issue that


focused on how we could find commonalities between one another, and to do so, I got to thinking about all the ways that we’re different. We have different passions, different pastimes, different perceptions. Really, the only thing we all have in common is Staples.
The fabric of Staples isn’t something homogenous and simple. It is complex, with varied patches, stitches and colors, and looking at it from a higher perspective, it is something beautiful. I wanted to create an issue that honed in on these various, one-of-a-kind patches. This magazine is divided into three sections. Tailors, people who better the community by teaching and guiding others. Patchwork, the various communities that form within Staples. And The Hem, the important community figures who make an impact outside of the halls but are just as significant.















large: as well as A Seat for Everyone (pg. 37), a theater provides meaningful and engaging employment to people with disabilities. These stories highlight the goal of this paper, to spotlight those who bring people together through art, communication and shared experience



















































































Some of the stories that encapsulate the message of these sections are Folded Futures (pg. 7), which highlights a club that uses art and creativity to support a cause halfway across the world: or Behind the Lens (pg. 25), which features some of the photographers and video editors that bring sports updates to the community at















A new club provides aid through art to an underfunded school in
Of course, none of this would be possible without my extremely devoted team of editors, who constantly stun me with their capability. In addition to being incredibly talented, I had the most fun working with all of them, and without any one of them publication of this paper would have been impossible. I’d also like to give a fond thank you to everybody in Inklings who drew, read, wrote and let me bug them for this paper. And of course, Mr. DelGobbo and Ms. Fulco, the teachers with the most patience and insight, and who lead the most devoted organization I’ve ever had the pleasure to be a part of.




















After overseeing this issue, I’ve gained a new appreciation for all the hard work that goes into quilting, and helping to patch this issue together has been some of the best fun I’ve ever had.










-Jack Robinson






















































































































































































































































































these stories highlight the Staples ‘tailors’ who celebrate the unique patterns among us.































said. “Art is something that brings peo gether… anyone can make it.”
That belief, combined with personal experi ence that reshaped her sense of social responsibility,
sparked the idea for a club that turns creativity into community support. Last year, while visiting Sri Lanka, Periyapperuma

by Malena T

ran art workshops at her cousin’s school for students with special needs. The students painted and folded flowers, turning each piece into something that that the school, Chapmika Academy, was struggling to afford rent and stay
a place where they can learn like we do.”

“There aren’t a lot of special needs schools in Sri Lanka, and even fewer that are well-funded,” she said. “I felt that I could try to help them so these students can have
Periyapperuma used that experience as inspiration to start the club Folded Futures at Staples this year, and with support from her mom, who helps precut paper for each meeting, she launched it with the hope that

selling the handmade flowers could sustain the very school she connected with. Since then, the club has raised over $1000 to donate to Champika Academy and to St. Vincent’s Special Needs Services in Trumbull. But, the work is more than fundraising.
“Making and selling these flowers feels like spreading a little bit of joy,” she said. “No matter how someone’s day is going, we can give them a little bit of color to brighten

to find programs that met his needs.” she said. “So even if it’s donating money every month, I like being able to contribute to that support.”
During fundraisers, people often stop by the table to share their own experiences with special needs education or care. Those moments, Periyapperuma says, have become some of the proudest in this journey.

what we’re doing,” she said.
While she leads outreach to organizations and teaches the members how to craft the flowers, Periyapperuma gives credit to her co-president Olivia Murphy for connecting with club members and keeping meetings running smoothly.
Looking ahead, Folded Futures hopes to grow to expand its influence outside of Staples and to other schools.
“I hope we’re able to inspire other schools to make their own Folded Futures clubs,” Periyapperuma said. “There’s such a need for awareness and support for special needs education.”

“It’s really nice that we’re able to have those conversations and connect with people who understand the importance of


PAINTING BEYONG LIMITS Jon reflects her belief that creativity is not limited by physical differences by using her feet to paint vibrant pieces.




Sophie Smith ʼ26 Editor-in-Chief
Artist Rosie Jon recalls that from a young age, art was not just an interest, it was instinct. She spent her childhood drawing and painting, though she uses a unique tool for her artwork — her feet. Born without forearms, Jon began picking up a pencil with her toes as early as one year old.
“In Korean tradition, on the baby’s first birthday, they always have a few items in front of them and the baby gets to pick an item that symbolizes the future,” Jon said. “I apparently picked a paintbrush, so I feel like being an artist was kind of part of me from the beginning.”
Born in the U.K. and raised
in South Korea, Jon has always loved painting. But it wasn’t until Jon had children and settled in Westport that she began participating in live art events.
“
es, and teach them anything is possible with encouragement and hope.
There’s nothing impossible and we are to embrace our differences.”
“I think one of the best things about being a mom is that my children are always inspiring me to be less afraid,” Jon said. “The beauty of being a child is that fear doesn’t hold you back.”
Now, Jon has painted in front of countless audiences—from school classrooms to trips around the globe.
Her life mission is to inspire other people to embrace their differenc-

She has painted in front of many current Staples students at their elementary schools, and most recently, she went on a service trip to Uganda, where she visited a disability home in Kampala.
“It really doesn’t matter what your circumstances are. It’s all about having that faith, to truly know that you are loved and that you are enough and
that your life has purpose,” Jon said. “Your difference is what will give you the superpower to fulfill the lives that you’re destined to live.”
She recently moved to London, where she continues to paint and connect with young children.
“I’ve been really blessed to have had these opportunities where I do get to show my story and inspire others that, really, there’s nothing impossible and that we are to embrace our differences,” Jon said. “Nothing can really hold us back.”

TEN TOES From creating vibrant works of art with her feet to teaching kids in Uganda how to do the same, Jon shows that creativity has no limits.

stickers wave in the hands of elementary schoolers, each marking a small but meaning ful moment. Back in the halls where their stories began, high schoolers are turning their own growth into a wave of kindness across Westport’s younger gen eration.
began in 2010 when four Westport mothers, each work ing as educators or counselors, partnered with the Anti-Def amation League and Westport Human Services to launch a kindness program for third graders at Long Lots and Co leytown Elementary.


filter across the five elementary schools teaching a different lesson each visit. Their visits include an icebreaker, watching a video then discussing the main idea and doing a hands-on activity that is personal to the students.
What makes K2BK so impactful is the passionate high schoolers involved, dedicated to guiding younger students towards kindness and positive influence in the district. Around 50 Staples students attend each










to remember their potential as leaders. The goal of this activity is to share how small acts of kindness can have a substantial impact.
“When I was in elementary school I remember loving when the high schoolers would come and talk to us,” K2BK member Dylan Johnson ’27 said. “Being able to return to my elementary school and give that same ex perience to the current kids at CES [Coleytown Elementary] is so special because I know that experience had an impact on me when I was in their shoes.”
Originally run by volun teers, the program has since expanded into a town-school partnership led by health teach er Kelly Shamas and Human Services Director Elaine Daig nault. Together, the two club advisors support high school mentors as they teach lessons of empathy and leadership to ele mentary school student coun cils.

“It’s gone from scripted lessons to more organic activities and discussions that stem from the high school student mentors’ experiences,” Shamas said.
“The lessons I teach at Kool to Be Kind not only teach the children,” K2BK member Aideen Kennedy ’26 said. “They

kshamas@westportps.org & edaignault@westportps.org



Eva Matviyenko ʼ27
Broadcast
Manager
Bianca Mastocciolo ʼ26
Creative
Director
In a school as large as Staples, it’s easy to feel small. Crowded lunch tables and packed hallways can easily make you feel out of place and alone. But among all the chaos, acts of kindness play a huge role in feeling connected with peers and creating community. Just a few kind words can turn around a day.
As children, we were constantly reminded of the importance of being kind and to “fill each other’s
buckets.” Now it feels like this concept has been lost in grades, game wins, SAT scores and an unspoken pressure building at Staples.
We were inspired to reinstate a kindness initative by conducting a social experiment to see how many students would take time out of their days to do an act of kindness.
To start, we created a kindness box in the library, where students could write notes (at their own will) to someone who might need a kind message.
Over the course of two days, over 30 students stopped to leave a note. The notes were heartfelt and thoughtful.
Here are some of our favorite anonymous notes:
“Even baby steps are progress… keep going!”
“Everything you do has a purpose.”
“You’re smarter than you give yourself credit for! Keep trying.”
“You are amazing for who you are.”
The power of encouraging words is one that Staples

Cut me out, write a kind message and give it to someone!


students should take more advantage of. A simple “I’m proud of you” leaves lasting positive impacts.
We understand it’s hard to radiate positivity when you slept only five hours the night before, but we truly believe a little more effort can go far.
So this is our message to you:
Make Staples a kinder place day by day. Joy can be so contagious when you actively choose to be kind. There are almost 1650 students in this school who face stress and competition, but there are also
1650 young and smart kids who all deserve to enjoy each day of high school.
So smile more, hold doors, go to the club meetings that you signed up for, ask the lunch staff how their day is and continue to work towards a level of kindness at Staples we






Jack Robinson ’26 Paper Managing Editor
After a young artist puts hours of effort into their piece, where does it go? More often than not, nowhere. No matter the medium, student artists typically lack the ability to break into local artistic markets and truly make a profit off of their hard work. The Students Opening Local Displays collective (SOLD) counteracts that by doing just as it states in the name: getting student work in front of audiences both face-to-face and through the internet.
“As someone who has taken around seven art classes at Staples
local display and we had eight people sell their artwork, totaling to over $1000. These students received the money from the artwork sold and were able to put it towards their futures as artists.”
The promise of giving experience with selling art and getting in touch with buyers has brought artists from across multiple different mediums and styles to join.
“Lots of young artists may start with passion, but allowing them into festivals and involvement in business can let all the work pay off,” Sophia Sheng ’27 said. “This is crucial to keeping art alive. For instance, I made a friend during the festival that I'm still in touch with, and she still buys my paintings!”
Acknowledgement helps improve self-confidence, encourages creative growth, and allows for constructive criticism." “
- Dylan Endich ’26
Jordan’s personal reason for starting the club stems from the issue of not being sure of what to do with all of her artwork.

I had the foundation to explore my painting in my free time,” Chloe Jordan ’26, founder of SOLD, said. “In all our arts education, however, none of us had ever received any instruction in navigating the realities of the post-school world. That's when I decided to start SOLD.”
SOLD gives students the option to sell their work in a variety of local art sales or on their website, meaning recognition for the effort that might otherwise go unnoticed by the wider community.

“There are 19 people currently presenting artwork on the website,” Jordan said. “In July, we had our first
“For my birthday [in 2024], I got an oil painting set and immediately I fell in love with the medium [...] I began painting so much that these experimental paintings filled my room like books on a bookshelf,” Jordan said. “I figured that similar things were happening to other artists at Staples. We were all creating without our art being able to go anywhere or meet anyone.
SOLD truly gives artists the chance to go out into the world and meet their audience firsthand: the many opportunities to sell at art festivals and engage with customers are some of the biggest draws to student artists.
“I think it's important be-
cause acknowledgement helps improve self-confidence, encourages creative growth and allows for constructive criticism,” Dylan Endich ’26 said.
Whether it be pencil or paint, Staples artists who may have previously been unsure of how to sell their art, or how to get started with their future artistic careers, can find a place to begin in SOLD.
“Speaking from my own experience, younger artists never
know how to involve themselves in a wider community such as selling art,” Sheng said. “So having something as accessible and welcoming as SOLD is a huge step to artists finding their way.”


Chloe Mitchell ’28 Paper Editor
For Chloe Jordan ’26 and Nina Katz ’26, dance provides more than just an outlet for their creative passions; it also allows them to teach the gift of dance to young students who may not otherwise have the opportunity.
Dancer’s Exchange, run by Jordan and Katz, partners with Lighthouse volunteers, a youth service program, to bring dance to Bridgeport schools. They typically work in classes of 20 to 40 kids during the second semester of the school year, with most of the public elementary schools participating.
“A lot of the time the families in Bridgeport can’t pick up their kids after school because they work longer hours,” Katz said.
Each elementary school has its own performance for the students that is learned over the course of a few months. Throughout this time period, there are weekly classes where
ment of the day of freedom [and] of expression and creativity is really important,” Jordan said.
The club offers the opportunity for students to try the class before committing to it. After a few weeks, the leaders start to put together formations and choreography, so the final class will be determined around their fourth week of teaching. These classes range in age, with some being third to fifth graders and others being kindergarteners. Nonetheless, each level brings its own difficulties and challenges to the table.
who are just awesome listeners.”
During the first semester of the school year, students work to raise funding and get resources for the students. Club members organize dance wear drives and different fundraisers so that kids have the proper attire for classes.
“Leotards are very popular, even gymnastics leotards, because they really can
“The students were so excited for us to be there and come and see them.”
-Chloe Jordan ’26
colorful. The kids like them, and [also] jazz pants,” Katz said.
Members of the club ensure that the chosen costume is ac cessible to all students.
[...] the funding that we’ve achieved through our drives,” Katz said..”
Throughout a few months, the bond within the group grows stronger and stronger. It goes beyond just dance classes, and it becomes a second home for students. Not only that, but dance can also improve quality of life. The National Library of Medicine reported that 95% of individuals said dance classes have helped improve their mood and decreased depres
“It depends on the environment of the school, and every kid is going through their own set of difficulties and hardships, as is any child,” Katz said. “We’ve had some really amazing kindergarteners
“We will go out and we’ll get that for them us ing




Jordan said.
As the club continues to work with more schools, they strive for more resources for the students. Their goal is to make their dance experience as professional and realistic as possible.
“Something that we’re looking to do in the future is more hair supplies. Because for performances, the kids, we like them to have their hair neat, and the way that we would present ourselves on stage,” Katz said. “We want them to learn how to do the same thing. It’s a part of being a dancer.”











the following stories explore communities that make up the ‘patchwork’ofStaples.










Madeleine McMahon ʼ28
Paper Editor
Juliet Varsov ʼ28
Paper Editor
You step out of the cold, anxiety-inducing classroom, just having finished a test that has been eating you up for weeks. Despite it being finished, you are still searching for a way to release your stress. When you see this friendly, furry face and wagging tail in the hallway, a wave of relief washes over you, replacing that stress with a sense of peace.
From exam weeks to times of crisis, therapy dogs at Staples have been a constant source of community and comfort for students and staff. This began when English teacher Brian Tippy brought forth the proposal to bring therapy dogs to Staples.
Tippy has been training his personal pets to be certified therapy dogs for twelve years. He started out using his dogs to help hospice patients and nursing home residents. Comet was Tippy’s first therapy dog.
Comet was trained at Paws and Effect in Hamden, Connecticut and certified through Canine Good Citizen. After years of working with adults, Tippy considered bringing his dogs to support students’ emotional well-being at Staples. After several requests from Tippy and multiple school counselors, certified therapy dogs were finally permitted to come to school.
“At this point, after we’d been asking for a long time, we finally got a, ‘yes,’” Tippy said. “So, we made a plan to do it. I already had two registered dogs at that time so I was allowed to start here.”
Tippy says his dogs are therapy dogs because they have always been more interested in people, with a fondness for interaction that can’t be trained. They also tend to be more sensitive than other dogs, often responding to how a person feels with just the right reaction.
to know to be a little quieter and if somebody wants to play, they seem to know to be a little more excited,” Tippy said.

Art teacher Angela Simpson owns another one of Staples’ beloved therapy dogs, Teddy. Similar to Tippy’s dogs, Teddy has always been very friendly and comforting, long before he was certified.
“When I saw another teacher, Mr. Tippy, who brings his Goldens here, I was like, ‘I bet I could get registered and bring Ted to school,’” Simpson said.
Teddy comforts students during stressful times such as midterms and finals week, but also during times of crisis. Last year, when a student tragically passed away, Teddy was there to provide his support.
“A lot of students were feeling pretty despondent […] I shared Teddy with my students, but the one that stood out in particular was finding someone crying, and I went up to them with Teddy and asked if they could use a little puppy love and I think it helped,” Simpson
They feel that it helps relieve stress in times of high pressure and create a sense of comfort across the school.
“They’re really nice to see during midterms and finals, and they really bring up my mood,” Jordan Benaderet ’28 said.
Therapy dogs have become a meaningful part of the Staples community, especially when it’s needed most.
“When tragic situations happen,” Assistant Principal Jim Farnen said, “we have a crisis team and we say, ‘let’s bring in the dogs.’”
PAWS FOR A CAUSE Art teacher Angela Simpson’s certified therapy dog, Teddy, comforts students with cuddles and calm energy during school wellness moments.








































SWill Enquist ʼ26
Paper Managing Editor
he shoots, she scores! In an instant, the stands erupt in excitement. While teammates run up to each other in celebration, students with cameras and microphones in hand race to capture the action on the court. Within hours, these images and clips flood social media, showcasing the most defining moments of each game. Inklings spoke with a couple of Staples’ established and emerging sports editors and photographers to learn more about their experiences.
Ryan Allen ’27, known on Instagram as @rka. visuals, began his sports photography and videography journey after taking media teacher Geno Heiter’s Advanced Video Editing class as a freshman. There, Allen met Charlie Scott ’24, one of Staples’ most prominent sports videographers at the time.
“Charlie took me under my wing and introduced me to a club called STV (Staples TV) where I got to edit and make break videos to be played between segments of live shows,” Allen said. “From then on, I bought my first camera and started shooting my own footage of sports teams, spiraling into what I continue to do today.”
Allen’s favorite part of the photo and video process is

and it helps you to push through all the hours you spend filming and editing,” Allen said.
During his time at Staples, Allen has borne witness to many incredible games, but he ranks the boys’ soccer team’s 3–2 victory against Greenwich in the FCIAC final above the rest for multiple reasons.
“I had watched the team from the start earn their spot in this final, [...] I had seen them start at their lowest and rise to the top, which was in credible to me, and I was so grateful to document their journey,” Allen said. “It was also my brother’s senior year, and to see him win everything meant so much to me as a brother.”
Allen’s career in sports me dia is just beginning; he plans to major in the field in col lege and hopes to one day be a content creator for an NFL or NBA team.





John Walker ’29, known on social media as @walker_.media, began capturing games after being photographed as a player himself and wanting to experiment with it on his own. He started with editing and taking photos on his phone, and has since transitioned to using a professional-grade camera.
“I’m able to be creative
with it and meet a lot of new people,” Walker said.
So far, Walker has found the most fulfillment in photographing soccer, with working outside on the field being one of his favorite parts. He had the chance to capture the historic soccer state championship, documenting the program’s first win in a decade and a half.
“I got [to go] into the locker rooms, onto a stadium field and [use] a media pass,” Walk-
Charlie Hannon ’27, or @shots.by.hannon on Instagram, started taking photos of the football team just this past fall, documenting one of the Wreckers’ most notable games of the season against West Haven. Hannon credits his success to the environment in which he shoots, with being able to exist between the field and stands making his newfound interest more exciting.
“I’ve always thought being a sports photographer would be fun, especially capturing the football team on Friday nights,” Hannon said.
He is most experienced in working with the football team, but intends to continue
to capture sports throughout the spring season. Hannon isn’t sure if this pursuit will translate or influence his career choices, but remains open-minded about where this work will take him.
“I’ve been having a great time,” Hannon said, “... and am excited to see where [this] takes me.”

er said. “That was a super cool experience for me.”
In the winter season, Walker creates edits for the girls’ and boys’ basketball teams, and is excited to see what opportunities the spring sports season brings him. His work has been featured on both PrepZone and Dan Woog’s 06880 websites, but Walker is unsure if he will continue to pursue sports media in college.
“I may pursue a career related to sports photography,” Walker said, “because I [do still] like it.”







Best Buddies, presided over by Maddy Johnson ’26, focuses on making a more inclusive environment for students with intellectual development disorders (IDDs) by meeting every other week and doing fun activities together.
Every student with an IDD gets paired with one of two club members. These pairings often blossom into real friendships.
“[Members] Lily and Ila

Walking through the club fair, there are countless tables lined against the walls. With so many clubs and so many different goals and subjects, it is hard to understand the deeper meaning and impact they have. While around 59 of the over 150 clubs at Staples are community service oriented, they are not thoroughly recognized for their hard work on making Staples and the broader Westport community a better place.
Teen Awareness Group (TAG) is striving to make the students safer and healthier. This non-profit’s main focus is on bringing mental health and substance awareness programs to Staples.
“[I] believe it does a great job of raising awareness of substance abuse and mental health disorders around Staples,” covice president Natalie Sipsma ’26 said.
have become really close friends from this club and it is cool to watch their friendship bloom from afar,” Johnson said.
Not only does this club in spire friendship and inclusivity, but it has been creating a sense of community as well.
“I’ve noticed that since last year and this year, people are growing a passion for it and wanting to be a part of some thing,” Johnson said.
This is a common problem seen in teens and in high schools all around the country. They can feel a pressure and urge to use substances for either social purposes or mental ones. It then becomes hard to talk about with the stigmas surrounding the issue.
While there is work that still needs to be done around the stigmas surrounding drug use, there is no doubt that the
club has still made a significant impact on the Staples community.
“I have seen TAG affect the environment surrounding mental health in positive ways, specifically in helping to decrease stigmas surrounding the issues we raise support about,” Sipsma said.

FINDING FRIENDSHIPS Best Buddies, led by Maddy Johnson ’26, holds meetings gathering students with IDDs with buddies to have fun making crafts, or just making connections.

AWARE (Assisting Wom-
en through Resources and Education) club, founded by Westport resident Amy Saperstein, focuses on improving the lives of women and girls by partnering with a new organization each year.
Willa Shamie ’27 is a member of the Staples AWARE club.
“It’s definitely made a big impact on the partners that we have. We are with Homes with Hope this year, so we will be doing a lot of food drives and stuff like that,” Shamie said.
AWARE is not only at Staples; it’s also in neighboring towns such as Wilton, Ridge-
field and Weston. All are connected to a larger community.
In addition, all of Amy Saperstein’s kids went to Sta ples and helped bring the club into the Staples community.
“I joined this club originally because I liked the community-building aspect of it, and how all the women supported each other,” Shamie said.


SPREADING AWARENESS
AWARE, founded by Westporter Amy Saperstein, dedicates itself to equal opportunities for women.
Georgia Ratcliffe ʼ27
Web Opinions Editor
Fairfield County saw a 19% increase in homelessness in 2023, according to National Public Radio. For Homes With Hope, this type of data is not only worrying, but a motivation to create change.
Homes With Hope is a

Westport-based organization that is dedicated to ending homelessness and malnourishment in Fairfield County. What makes this organization special is not just the work accomplished, but the student and youth participation. For years, Staples students have come together to volunteer and organize fundraisers.
“I decided to join Homes with Hope because I’ve been very passionate about volunteering all throughout middle and high school,” President Aiden Hill ’26 said.
Originally opening in 1984, Homes With Hope started with just a retired firehouse, which was then repurposed to become a homeless shelter for single men across the county.
Since its incorporation, the organization has significantly grown in size and impact. According to their website, in 2024, members of Homes With Hope supported 1310 members of the community by providing meals to families, supporting the underprivileged youth and offering housing arrangements for those in need.

“My favorite part is definitely meeting new people at the food pantries or new students who join Homes with Hope,” Hill said. “We are a very tight-knit group of kids, and everyone is always very creative and smart when it comes to thinking of new ideas.”
A NEW HOPE Homes with Hope, led by Aiden Hill ’26, is a nationwide organization that holds canned food drives in support of unhoused communities.


Ella
'28 Paper Editor

Most A.P. classes are deep in the trenches of their lectures, 10 page essays, and unit tests. Where creativity feels like a foreign concept; however, one A.P. class stands different from the rest. Currently curating their personalized portfolios, A.P. art has been hard at work, with each individual student using their unique perspectives to create what they call a “sustained investigation.” From musical connections to the hero’s journey to the concrete jungle, A.P. art has been putting their creativity to good use.


and throwback
and throwback
For her sustained investigation, Jessie Zhang ’26 has chosen to transport herself through the time machine of high school, all the way back to English 9 Honors and the concept of the Hero’s Journey.
“I’m going to do one piece on the ordinary world, which is the first world that you live in,” Zhang said, “and some [other pieces such as] ‘call to adventure’ and ‘meeting the mentor.’”
As for her inspiration, Zhang has decided to travel even further back in time to the 1600’s, where she hopes to achieve the Baroque art style.
“It’s a European art style,” Zhang explained. “They have this technique… very dramatic lighting…and its emphasis is on storytelling.”





As a former New Yorker herself, Isabella Larson ’26 is preparing to share her view of New York City from both the insider and outsider perspective. There is one thing she can certainly contest, and it is that the current reality of the city has dramatically changed from her memories of the place in which she spent her childhood.
“My [sustained investigation] is on memory, and the question ‘how can I memorialize places I used to live?’” Larson said. “I used to live in Manhattan, and whenever I visit, it's just not the same anymore.”


Emersyn Miller ’26, like most, has used her sustained investigation as a way to tie back into her passions. As a member of a band named Anhedonia, she hopes to represent her love for music and the musical community through her pieces.
“It’s basically representing the music we make as well as our own friendships and bonds,” Miller said, “through posters, merch and album covers and such.”
Miller is not only using AP Art as a way to express her passions, but also as a way to expand her comfort zone by trying new styles of art she was not previously accustomed to.
“I’m trying to branch out into a more cartoonish style because I usually draw lots of realism,” Miller said. “Later I’ll hopefully branch out into either more story, comic book-like things and then also more realistic album covers.”
Miller’s idea has gone through many revisions, however she has ultimately decided the best way to connect with her audience is to represent her camaraderie with her bandmates, more so than the actual music itself.
“My original sustained investigation was going to be representing the meaning of the song through visual art rather than auditory,” Miller said. “I decided to branch off of it and kind of do something with the actual members of my band… a big motivation for me is how close I am with them.”



Brooke Kirkham '27
On the Wreckord Producer
Over the past few years I've learned what it's like to be “the new kid.”
Not once, but three times. From Trumbull to London, London to Dublin, Dublin to Westport, my family has packed up and started all over again many times. My dad’s job meant new cities, new schools and an entirely new set of people to meet. What I didn't realize at first was that each move would teach me something deep about connections, courage and the power of kindness.
Every move started with a heavy mix of excitement and fear. On the outside it looked like a fresh start, but on the inside I was terrified. Walking into a new school where everyone already had their groups, their inside jokes and their routines was incredibly overwhelming. Eighth grade was especially hard. Everyone seemed to know where to sit at lunch, what to wear, how to talk and I didn't. It's one thing to start over once, but once you do it again and again, you start to wonder if you'll ever fully belong anywhere.
What I've realized, though, is
that connections often start in the smallest, most unexpected ways. A quick “hi” in the hallway, someone holding a door open or a simple compliment can change an entire day for someone who feels out of place.
I remember in eighth grade, a girl offered me to sit at her lunch ta-
ble and we are still very close to this day. The first person who talks to you when you're new might not realize it, but that moment can stick with you for months. That's why I've learned to always keep an open mind and heart because every conversation, no matter how small, has the potential to become something meaningful.




Over time I realized that community isn't just something you're born into, it's something you build. Another moment that stuck with me was in eighth grade when I was going to soccer preseason for the first time. I was completely nervous and not just about playing. I didn't know what to wear, what time exactly to arrive or what people usually did before practice. That feeling of uncertainty made me feel like I didn't belong, even before I stepped onto the field.
After that first preseason practice, one girl from the team texted me out of nowhere. She told me exactly what to wear, where to meet and what to expect the next day. It was such a small thing, but it made a huge difference in my confidence. That girl didn't have to reach out, but she chose to, and because of that I felt included before I even realized I needed it.
Being open to new people isn't always easy. It's human nature to stay in your comfort zone, especially when you feel out of place. If there's one thing reading this teaches you, it's to take that first step and talk to someone new. You never know when a small gesture like sending a text or saying hello can change someone's entire experience and make them feel like they belong.









Serena Goldfarb ʼ28 Paper Editor
Classroom 3034 may seem unsuspecting at first; however, if you peek inside, a whirl of students with lab beakers, pipettes and a multitude of ideas is evident. One student is looking at flies under a microscope, another is prepping petri dishes for worms and one teacher is bouncing around the classroom checking in with students. However, no matter what task they are accomplishing, they are all working together as a science community.
Science Research Honors, a class taught by science teacher Amy Parent, is one of the most unique classes Staples has to offer as it is personalized to each student. In this class, students are able to create their own curriculum which revolves around one experiment.
“Designing my own experiment is especially rewarding because it allows me to investigate questions that genuinely interest me,” Elise Yang ’27 said.
For those interested in anything from marine biology to astrophysics, this class offers the opportunity to explore those passions in depth and in a multitude of ways. Science Research allows students with a passion for science to be able to use higher quality experimental tools not offered in a traditional science class at Staples.
“I can choose a real life problem with a knowledge gap to look into such as anxiety, so I ended up looking into depression which has been so interesting,” Hayley Epstein ’27 said.
This class also allows students to experience a more professional lab setting, as it is equipped with advanced lab materials, such as shaking water baths.
“The cutting edge scientific technology that I wouldn’t have been able to encounter otherwise is what makes this class my favorite,” Yang said.
Since this class is tailored to every person, students develop a sense of independence and spend lots of time in and out of school in the lab. They share an experience of being independent but they also share the same sense of community.
“The students are responsible for their work, and so their success they totally own it, and I’m here to support them,” Parent said.
Overall this class allows for scientific creative freedom with a community of people producing original scientific work.
“My favorite part is the freedom that Mrs. Parent gives
her students,” Jay Hari ’26 said. “They make their own research projects, do their own experiments themselves and adapt to any challenges when running those experiments.”
The students are responsible for their work, and so their success they totally own it, and I’m here to support them. “ - Amy Parent



meet community figures who make up ‘the hem,’ that holds Westport together.

Camille Blundell ’27
Creative Director

The lights don’t go all the way down at the Prospector Theater. The volume stays low. The lobby hums quietly instead of roaring. On sensory-friendly Sunday mornings, this independent theater in Ridgefield, Connecticut slows the world down on purpose...

At the Prospector Theater, moviegoing isn’t just entertainment. It’s belonging.
The Prospector Theater is a nonprofit cinema that opened in 2014 with a mission to improve the quality of life for people with disabilities through meaningful employment. Approximately 75% of the staff, called “Prospects,” identify as disabled. In a movie landscape dominated by streaming, this brick-and-mortar theater argues that gathering in a room together still matters, especially when that room is built to accommodate people of all abilities.
Accessibility is embedded in the theater’s operations, not treated as an extra. The Prospector regularly offers open-caption showtimes where the captions are right on the screen like subtitles, and closed-caption cups that you can pick up at the box office available for every screening. For anyone who is hard of hearing or deaf, this lowers the barrier to watching movies so they can follow along. Accessibility isn’t a flourish here; it’s a main mission. Sensory-friendly showings feature lowered volume, dimmed but not fully dark theaters, and a calming lobby environment. The goal is to allow more people to comfortably share in the communal experience of watching a film.
“We try to offer different ex-
periences,” Senior Operations Manager Shannon Connors said. “So no matter who you are, whether you are bringing your child and it is their first time seeing the movie or you have sensory sensitivities and find something overwhelming, we want you to still come in and have a great experience.”
That emphasis on welcoming extends beyond accommodations and into workplace culture. The theater’s philosophy centers on identifying each staff member’s “Sparkle,” which is a passion or a skill that can be developed into a meaningful role. Two employees, Brooklyn and Katie, both had their passions turned into their “Sparkles” at Prospector. Brooklyn was a cheerleader in high school, and Prospector gives her an environment to get up and perform outside of the football field.
“Ushering and giving speeches is one of my favorite things to do,” Brooklyn said.
Katie said she was really into graphic design, which was then turned into part of her job at Prospector.
“We do a lot of stuff in house instead of going to different companies,” Katie said. “Our graphics team does the signage to the flyer that goes around town to our box office. We even recreate some pop-
ular movie posters with the Prospects.”
“We like to match people’s passions and turn it into a profession,” Connors said. “If it makes sense and cents.”
The building itself reflects this mission. The theater sits on the site of the town’s original movie house, rebuilt and reopened after being slated for demolitions. The focus on meaningful employment is by design. After receiving her Masters in Special Education, founder Valerie Jensen went on to work as an executive director of an arts nonprofit for disabled adults. While working and developing musicals and films starring adults with disabilities, she noticed how many of her disabled friends were unemployed, and she made it her goal to provide meaningful employment to her community, no matter their ability status.




Prospector Theater is recognized by KultureCity, and a majority of the staff had to take a course to be able to recognize someone who might be struggling with an overwhelming sensory environment and how to best help them. KultureCity is the world’s leading nonprofit on sensory accessibility and acceptance, with their main goal to make “Nevers Possible” by creating sensory accessibility and inclusion for those

with invisible disabilities, like PTSD, autism, dementia and stroke victims. When you walk through the doors of the Prospector Theater, you will see a sign saying they are a “KultureCity sensory inclusive building.”
At the box office, you are able to rent a bag for your moviegoing experience that includes fidget toys, noise cancelling headphones, a weighted blanket and a little cue card that can help you communicate what you are feeling whether you are nonverbal or caught up in the moment that can tell the Prospects what they can do to help.
“It’s [differently abled] the only community that you can enter and exit at any point of your life,” Connors said. “You can be born with a disability, you can acquire a disability later on in life, so it’s important to be able to have spaces where they feel welcomed, feel like they have places where they can belong, be able to have a job and just be independent and have the same experiences everyone else does.”
Creativity also powers other parts of the building. In the five hundred square foot kitchen upstairs, the popcorn team is busy creating new flavors and branding for the Prospector Popcorn brand, a line of gourmet popcorn sold


and developed by Prospects.
“Sometimes we say, well, we play movies…” Connors said. “But we’re kind of in the pop corn business.”

Now, the business is “pop ping” off and the business is moving to a five thousand square foot popcorn factory as well as continuing to be sold in Nod Hill Brewery. The bag of popcorn creates many jobs. Like Katie said, the graphics team creates the logos and designs the labels. Then, you need someone to pop the pop corn, caramelize it, top it, bag it, seal it and then finally ship it all out.
At the Prospector Theater, moviegoing isn’t just enter tainment. It’s belonging. The familiar rhythms of the cin ema tickets torn, popcorn scooped, and seats found are carried out with the belief that everyone deserves to participate in the shared joy of a story on screen. The mission is simple, yet effective: a seat for every one.
“Creating it your own way with things that you have available,” Con nors said. “You don’t always need to create an accommodation or a way for someone to be able to get a job done, or for some one to be able to experience it.”

HEADS UP The pennies on the ceiling, each placed by Prospects, represent the feelings of pride brought about by meaningful employment.
“ a profession.” We like to match
people’s passions and turn it into
-Senior Operations Manager Shannon Connors



by




Catie Campagnino ʼ26 Associate Managing Editor
Local news is something that is important in every town. However, when you walk around Westport it is hard not to hear about the 06880 blog. What makes this blog important? It’s the face behind it: founder and executive editor Dan Woog.
In 2009, Woog thought that there was a lack of local newspapers. Woog wanted to have a voice in his town, so a friend suggested that he start a blog. He wrote his first 06880 post in March of 2009 and sent it to a friend who then spread the word. Within a day he had 100 followers. Sixteen and a half years later he has posted over 19,700 times, to his 20,000 followers and he has never missed a day of posting.
“I had no idea what I was doing, or where it was going. It evolved organically,” Woog said.
Woog shares all different types of news on his blog from sports to politics.
Woog isn’t a one-man show, since he has several reporters working for him. He also has a board of directors who do a wide range of activities, including one spot reserved for an Inklings staff member.
“They come up with ideas for new features; they assist with budgeting and fundraising; they raise issues and offer advice that allows me to best serve our readers, online and off,” Woog said. “Plus, they are a very fun group.”
ber is former Staples’s principal John Dodig. Dodig met Woog over 20 years ago when he be came principal and Woog was the soccer coach.
came aware of his love for West port and his knowledge about its history, “ Dodig said. “As the years progressed, I learned that he started the 06880 blog and asked if he would help me share with Westporters how special Staples is.”
Amy Saperstein, said that Woog’s blog has created a com munity for the town.
has an open forum to share ev erything from events, new busi nesses, local concerns and ways to help one another. There are so many wonderful connections between Westporters of all ages and walks of life that have met due to an article on 06680,” Saperstein said. “Dan enriches all of our lives for the better and we are so lucky to have him and 06880.”




Complete Dan Woogs’ headlines and Story to feel like you’re a part of 06880!
Headline Puzzle
1) Wait, What? The _______ was downtown?

2) ________ Westport: Spotlight On.....your _______
(company) (room
3) Stolen ______ follow up: don’t be a ______!

Story Puzzle
Congratulations, ________!

We made it through the _________ of ______.



Of course, it will take time to clean up all that ______. (Schools are closed tomorrow -- c’mon _______, get out there and shovel!)
The town was as ______ as it’s ever been today....Public and private crews worked long and hard, _________ roads and driveways. (C’mon, residents -- lend a ______ with the sidewalks and fire hydrants!)
Things will start edging closer to _______ tomorrow.

a house) (object) (noun) (place) (weather event) (year) (noun) (plural noun) (adjective) (verb ending in -ing) (body part) (adjective)



Zara Saliba ʼ26 Paper Managing Editor










small businesses are the backbone of any town: no one has ever visited someplace new and thought to themselves, “Wow, the Burger King here is so unique. What really makes a town have its own charm are the often-underappreciated small businesses that call it home. Luckily for Westport, it has its fair share of small businesses, ranging from clothing to restaurants to coffee shops, each with their own stories. The one-of-a-kind businesses that are unique to Westport are what gives the town its personality.
Middlemarch, a culmination of chic and whimsy accessories. Coming straight from the heart of jewelry enthusiast and merchant Sarah Caplan, Middlemarch is a collection of curated and one-ofa-kind jewelry, accessories and decor. From colors to design choices, every piece is something new to meet the eye, featuring zodiac coins and various


ocean-themed pieces.
Loved by many, Middlemarch is Caplan’s latest adventure in design, following Dovecote, her old business, named “Best De sign Store” by Architectural Di gest. Her taste extends beyond Dovecote to Middlemarch’s extensive collections, worn by many Westporters.

“This place is like a little jewelry box,” Dorothy, a salesperson at Middlemarch, said.

ONE-OF-A-KIND
Middlemarch, which opened in 2019 by Sarah Kaplan, is a jewelry store on Post Road E featuring pieces selected from artisans, goldsmiths, and estates around the world.









Bags, bikinis, anything can be charmed!
Jeweled Coquette is a collection of handcrafted jewelry and charms designed to sparkle up everyday life.
Some of their most popular pieces are colorful bon bon necklaces and charm sets, which can be used to dazzle up a bag or a bikini. Emily Blundell created Jeweled Coquette as a way for her to add more glam to her life and share that
with other people.
“I had been making jewel ry for friends for years before someone asked if I would like to try selling in their store,” owner Emily Blundell said.
“The real motivation [to start Jeweled Coquette] has been simply being able to share my creativity and art with others.”
One of the best ways to add a touch of personality to any outfit, Jeweled Coquette offers a wide variety of jewelry to add to your current rotation.

Savvy + Grace is a store full of Westport pride. From town merchandise to participating in town events like the Holiday Stroll, they do it all. First opening in 2017, their collection has had years of curation. Store owner Annette Norton was inspired by a town full of small businesses and in-person shopping when she developed Savvy + Grace, and sought to bring that life to Westport.

“It’s not just the same stuff you see everywhere (...), you go into an escape when you come here,” Norton said. “It’s sort of
like you’re on vacation because [we’re selling things] you don’t see everywhere else.”
Before putting anything on the shelves of this uniquely-curated store, Norton checks prices online to make sure customers are getting the best deal possible, oftentimes for more affordable prices and the benefit of quality services like gift wrapping. This is certainly a stop to check out if you love Jellycats, are curious about custom-designed town merchandise, or if you are looking for a new, comfy, home staple.

HANDCRAFTED GLAM
Jeweled Coquette by Emily Blundell offers handcrafted jewelry and charms that add a touch of glamour to everyday life.






Whether you’ve gone for last minute party supplies, or heard of the store from one of your friends who works there, there’s no doubt that Party Harty is the place to go for celebrations


Kerry Gale is passionate about maintaining a lifestyle that uses scents as a way to connect body, mind and home and is the creator of Floraco.

in Westport. The small business, run by Sue Marshall and her daughter Jackie, has been around for years, encouraging generations of Westporters to celebrate their milestones with balloon bundles, custom Westport gifts or any other classic

party goods.
From the balloon ideas posted on their website to the large array of items in store on Post Road, this small business has all you need to make your celebration visions come to life.
SUPPORT LOCAL
Whether it be Party Harty, Floraco or Hand Knit by Xoli, support the small business that bring joy, wellness and creativity to everyday life.
Featuring collections of aromatherapy blends, candles and soaps, this fresh take on a clean lifestyle is the prime example of mindful living rooted in love. Created in small batches to emphasize sustainable living, Floraco delivers on peaceful scents
Created by Xoli Ngcoza, a South African Certified Nurse Assistant, Hand Knit by Xoli was created out of her passion for knitting, which Ngcoza first developed as a way to connect with one of her Alzheimer patients in 2008.
“I was working for [this patient], and I just decided to


while also offering refills, to reduce their footprint and prioritize well-being, in and out of the body.


open a closet. I found yarn, and I said to her, well, why don’t you teach me how to knit because it looks like you’ve got old projects,” Ngcoza said. “My thing was to see if I could engage her into doing something new.”
Since that very first project in 2008, the business has taken off and Ngcoza has created an array of colorful, hand-knit

pieces like cable sweaters, hats and cardigans, made from Alpaca Yarn. This season, consider supporting a small creator and purchase some hand-knit pieces, made with love.
“I’m always creating my own patterns, and I’ll just put a special touch to it,” Ngcoza said. “It’s all just inspired from everything that I see. Do you see how gloomy it is? Color is very important.”







body for the day.”

Whether you’ve driven past the anachronistic, classic red phone booth on your way to downtown Fairfield or heard of the recent opening past Staples, Gruel Britannia has been around for years. Striving to bring the cozy warmth of British comfort food to New

England, the welcoming atmosphere like dining at a friend’s house helps guests enjoy a memorable experience rooted in authenticity and comfort.
“I love every aspect of food,” Chef Karen Hubrich said, “from finding the freshest ingredients to cooking and most importantly eating it.”



OThe goal of Gruel Britannia is to create an authentic environment, whether that be from their signature Full English Breakfast and Scotch Eggs or by selling Cadbury treats. Their community events enhance the experience of the food and make the dining experience worthwhile.

“Food is a great way to connect with people,” Hubrich said, “and for me to share what I have learned means a lot to me.”




Avni Krishna ʼ27 Associate Managing Editor
As the holiday season made its way to the eager residents of Westport, the only thing needed to make the holidays whole were Staples’ own Orphenian carolers. The Orphenians, a specialized Staples choir, have upheld a legacy of singing during the holidays since their creation in 1960. Starting as a way to give back to the community, the Orphenians repertoire of 12-15 acapella songs have remained consistent throughout the years.
The choir performs at venues like the Westport Women’s Club, the Westport Library and the Saugatuck Congregational Church. Over the last
current carolers to perform at the Westport Holiday Stroll, co-founded by 06880 and the Westport Downtown Association. All the proceeds donated during their caroling goes right back to funding the Orphenians.
But beyond bringing the Westport community together, freezing temperatures and all, Lauren Pine, the Staples choir teacher, brings it all back to the connections in the Orphenians community.
caroling event where they get to sing with people from 10 years ago. They love singing for the community. Seeing everybody’s faces light up when it’s a tune they know or again that holiday time, that is our favorite thing.”
The whole community shows up and they watch us sing.” “
- Liliana Gomez ’27
“It really bonds them be-
Even during the hectic Staples music schedule during the winter seasons, with caroling, Candlelight and preparing for performing at Radio City, the students were nothing less than eager to give back to the community that supported them
nity responses is when we carol at the holiday shopping stroll in downtown Westport where like the whole community shows up and they watch us sing, cheer us on and they donate,” Liliana Gomez ’27 said. “We just kind of bond when we’re all singing out in the cold because we’re all cold but we’re all still having fun together.”









DECK THE HALL The Orphenians became globetrotters this holiday season, traveling beyond Westport to





Liv Perry ’28 Web Sports Editor
Between juggling school, sports and social lives, high school students' hands are full. However, for the few that choose to clock in at work on the weekends, they might learn valuable lessons like managing money and people skills, but what they truly benefit from is the fun and unexpected experiences they have.
The unexpected memories are what makes having part time jobs as a high schooler truly unforgettable. They help create friends and leave students with stories they'll laugh about long after their shift ends.
Mia McDonald ’26 understands this as she works at the local toy shop, The Toy Post, and deals with life size giraffes.
“This lady paid with a check
and bought a life size giraffe. She was like, ‘Can you wrap it?’ and we said, ‘Okay.’” McDonald said. “So we had to lay this full size giraffe down and couldn't even cover its head because it literally used up all of our wrapping paper. And then she walked out with it.”
While wrapping lifesized giraffe stuffies might not be a daily occurrence for most working teens, all work and no play is a recipe for burnout no matter how old you are. Moments of levity at work serve as a reminder that joy has a place alongside responsibility.
at Birchwood Country Club, has many fun memories, some a bit shocking and others more chlorine-ey.
“We had to lay this full size giraffe down and couldn’t even cover its head because it literally used up all of our wrapping paper.
-Mia McDonald ’26
“One time, we were closing up and it was really cold,” Vindiola said. “I was working with my boyfriend at the time and he picked me up and threw me in the pool with all my clothes on and then everyone jumped in and my boss did, too.”
While there are plenty of fun moments to look back on, there are also some not-so-fun ones. Vindiola went on to recall an encounter she had with a blunt “customer.”
wasn't in my life guard uniform yet," Vindiola said. “I was in the bathroom with an older woman when she said ‘These lifeguards better start keeping this bathroom clean,’ and I was like ‘Oh, I think they really try to keep things clean’ and she was like ‘No, they don't do anything.’”
While listening to criticism is never ideal, the experience teaches teens life lessons about staying respectful and maintaining composure while also politely defending themselves during uncomfortable situations.
Liv Vindiola ’27, a lifeguard
SUMMER SIDE GIGS Lifeguarding, camp counseling and other part-time jobs not only provide money, but teach valuable skills.
“I was working as a camp counselor for the Club, so I
Overall, high school students who take on part-time jobs gain much more than just money. They gain memories and lessons that shape their futures. From hilarious and fun moments to challenging encounters, jobs are full of surprising and important experiences.












